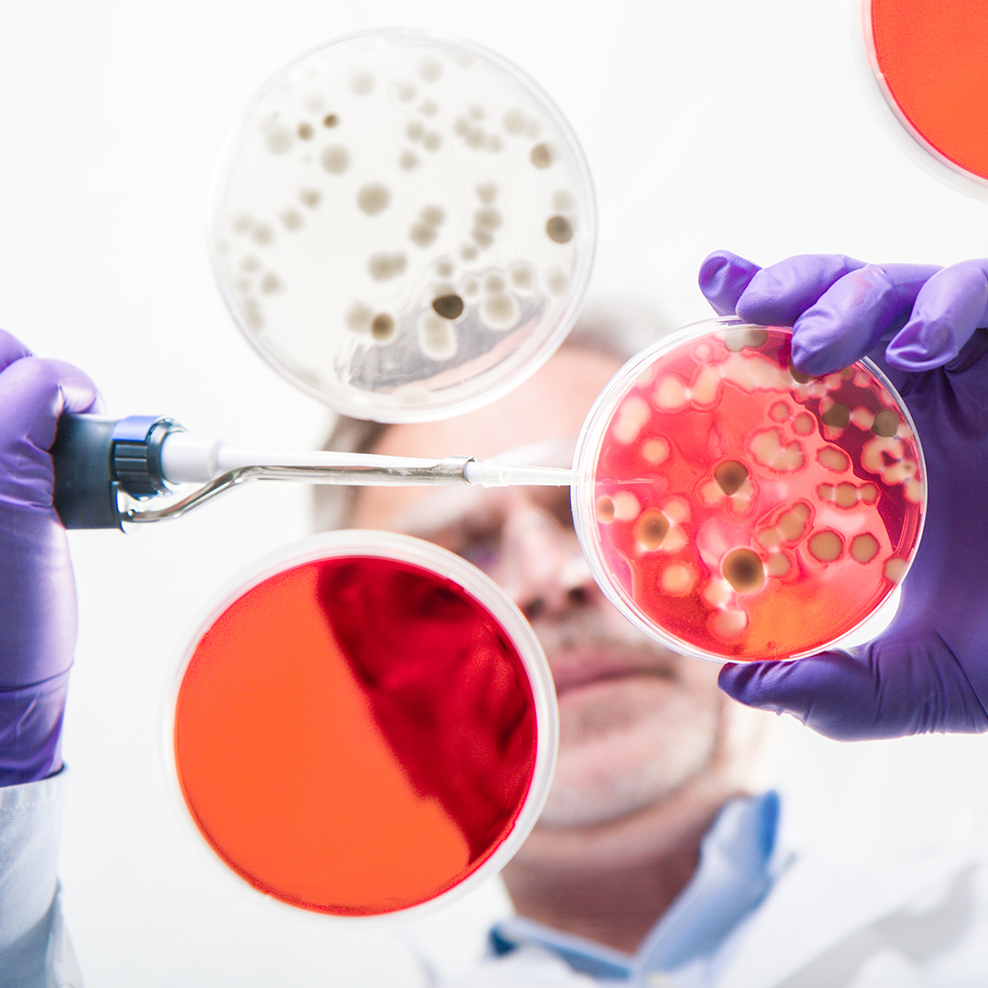

Life sciences
Precision and purity define life sciences environments — and Safe Monitoring Group delivers monitoring technology engineered to protect research, manufacturing and cleanroom operations. From low-level toxic gas detection to continuous environmental monitoring, our solutions safeguard people, assets and critical processes across pharma, biotech and laboratory settings.
CPC UK
CPC employ their own fully qualified engineers nationwide installing, servicing and maintaining our fully comprehensive product portfolio.
Bieler + Lang
For more than 50 years, our products have been providing timely and reliable warnings of gas accidents and explosions.
IGD
International Gas Detectors (IGD) develop, manufacture and market a complete range of gas detection products designed to protect people and plant against gas hazards in industry, research and commercial applications.
